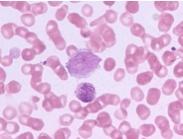

小兒熱帶嗜酸性粒細胞增多
628健康網(www.mk776.com)為您匯集最新關于小兒熱帶嗜酸性粒細胞增多的健康知識大全、小兒熱帶嗜酸性粒細胞增多最新消息資訊等有關小兒熱帶嗜酸性粒細胞增多的文章知識介紹,供您參考。
小兒熱帶嗜酸性粒細胞增多
-
小兒熱帶嗜酸性粒細胞增多癥
628健康網為您分享有關小兒熱帶嗜酸性粒細胞增多癥的癥狀,小兒熱帶嗜酸性粒細胞增多癥的治療方法,小兒熱帶嗜酸性粒細胞...
-
周鑫
周鑫,女,副主任醫師,熟練掌握傳染病婦產科常見病與多發病的診治,妊娠合并肝病、急慢性病毒性肝炎、肝硬化、妊娠期...
-
閉鎖綜合征
628健康網為您分享有關閉鎖綜合征的癥狀,閉鎖綜合征的治療方法,閉鎖綜合征的預防知識,閉鎖綜合征的癥狀圖片,閉鎖綜合征...
-
濟南市第二人民醫院
628健康網醫院大全頻道為您提供濟南市第二人民醫院簡介,濟南市第二人民醫院介紹,濟南市第二人民醫院怎么樣,濟南市第二人...
-
孟繁興
孟繁興,男,北京中醫藥大學東方醫院,腦病科,主任醫師、碩士生導師。畢業于北京中醫藥大學臨床醫學系,長期從事臨床...